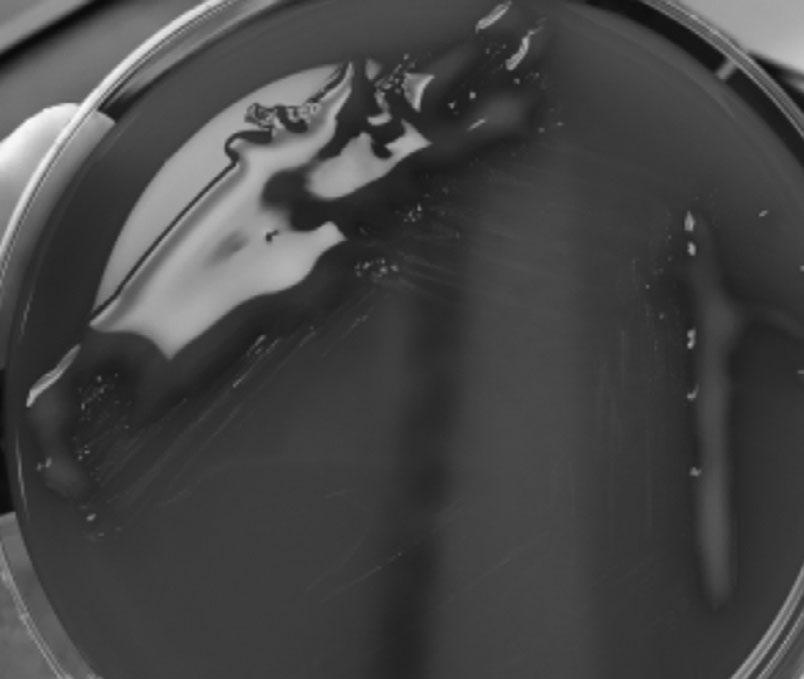

1 BiologyofBacteria,Viruses, FungiandParasitesandthe
Host–PathogenInteractions
Microbialandhostcellularbiologyandinteractionsdictatethebreadthofclinicalinfection practice,fromcolonisationtoinvasiontoinfection.Understandingtheclassifications usedforbacteria,viruses,fungiandparasitesaidsclinicalandlaboratorydiagnosisand ultimatelypatientmanagement.Understandingthecommonhostresponsestoinfective agentsatthecellularlevelenablesappropriateclinicalmanagementbothwithdirectacting anti-infectivesandothersupportivetherapy.
Questions
Q1.1A21-year-oldfemalepresentswithafever,andanovelviralinfectionissuspected. Electronmicroscopyisperformed.Whichofthefollowingmightbepresentin avirus?
A.Nucleus
B.Anenvelope
C.Metabolicpathways
D.Ribosomes
E.Acellwall
Q1.2A46-year-oldmalepresentswithafeverofunknownorigin,andawholeblood sampleissenttothevirologylaboratoryforpolymerasechainreactiontesting. ThetestidentifiesaDNAvirus.Whichofthefollowingclassofviruses containDNA?
A.Rhabdoviridae
B.Orthmyxoviridae
C.Enteroviridae
D.Flaviviridae
E.Parvoviridae
Q1.3A1-year-oldmaleawaitingrepairofaventricularseptaldefectisbeingconsidered forpalivizumabprophylactictherapyforrespiratorysyncytialvirus(RSV). WhattypeofvirusisRSV?
A.Single-stranded( )RNA
B.Single-stranded(+)RNA
C.Double-strandedRNA
D.Single-strandedDNA
E.Double-strandedDNA
Q1.4A21-year-oldfemalepresentswithafeverandleucopaenia,andaviralinfectionis suspected.Whichofthefollowingisaparamyxovirus?
A.Rubellavirus
B.InfluenzaBvirus
C.Poliovirus
D.Nipahvirus
E.ParvovirusB19
Q1.5A25-year-oldfemaleisrecalledaftercervicalscreening.Whichofthe followingistrueregardinghumanpapillomavirus(HPV)-associated malignancy?
A.HPV-6andHPV-11areassociatedwithgenitalcancers
B.HPV-16andHPV-18areassociatedwithgenitalcancers
C.HPVlateviralproteinsinhibittumoursuppressorgenes
D.HPV-6andHPV-11areassociatedwithanalin-situneoplasia
E.HPVlateviralproteinsareproductsofproto-oncogenes
Q1.6A27-year-oldfemalewithsicklecellanaemiapresentsinaplasticcrisiswithafever. Herbloodresultsdemonstrate:
Haemoglobin50g/L
Reticulocytecount0.1%
Whitecellcount12.3×109/L
Lymphocytes8.6×109/L
CRP34
Whichgenusisthemostlikelycausativevirusfrom?
A.Dependovirus
B.Henipahvirus
C.Pneumovirus
D.Parvovirus
E.Erythrovirus
Q1.7A31-year-oldfemaleisreferredfromoccupationalhealth.Achronicinfective carrierstatemayoccurinwhichviralinfection?
A.Hantavirus
B.HepatitisAvirus
C.HepatitisEvirus
D.HepatitisCvirus
E.Nipahvirus
Q1.8A54-year-oldmalepresentswithfever,tachycardiaandhypotension.Ablood cultureistakenandbecomespositivein12hours.TheGramstainisshownin Figure1.1.
Figure1.1 Gramstainfroma positivebloodculture.(Ablack andwhiteversionofthisfigure willappearinsomeformats.For thecolourversion,pleasereferto theplatesection.)
WhichofthecomponentsoftheGramstainisafixative?
A.Safranin
B.Carbolfuchsin
C.Acetone
D.Crystalviolet
E.Iodide
Q1.9A54-year-oldmalepresentswithfever,tachycardiaandhypotension.Ablood cultureistakenandbecomespositivein12hours,and Escherichiacoli is identified.Itisdemonstratedtohaveinvitroresistancetomanypenicillinsand cephalosporins.Throughwhatmechanismisanextended-spectrumbeta-lactamase genemostlikelytobepresentinthis E.coli?
A.Transduction
B.Transformation
C.Conjugation
D.Constitutively
E.Denovomutation
Q1.10A28-year-oldmalepresentswithdiarrhoea.Anon-lactosefermentingcoliform isisolatedfromfaeces,andserologicalinvestigationoftheisolateisperformed. The “O” antigenispositive,butthe “H” antigenisnegative.Whatisthemost likelyexplanationforthis?
A.Theisolateisnon-motile
B.Theisolateneedsboilingpriortoagglutination
C.Thepresenceofa “Vi” antigenismaskingthe “H” antigen
D.Theisolateisinanon-specificphase
E.Theisolateisnota Salmonella species
Q1.11A35-weekpregnantfemalerecalledaflu-likeillness2dayspriortodelivery.Shewas treatedforperi-partumsepsis,andhernew-bornchildwasborninpoorcondition andadmittedtotheneonatalintensivecaredepartment.Bloodcultures(andsubsequentlycerebrospinalfluid)grewtheorganismdepictedin Figure1.2.
Figure1.2 Gramstainof cerebrospinalfluid.(Ablackand whiteversionofthisfigurewill appearinsomeformats.Forthe colourversion,pleaserefertothe platesection.)
Whichlaboratorytestwouldbethemostusefultoconfirmidentification?
A.Coagulase
B.Catalase
C.Oxidase
D.Haemolysisonbloodagar
E.Tumblingmotility
Q1.12A34-year-oldmanpresentswithafever,andanaerobicbloodculturebottlegrows aGram-negativerod.Whichoneofthefollowingorganismsisastrictaerobe?
A. Bacteroidesfragilis
B. Kluyvera spp.
C. Proteusvulgaris
D. Prevotellamelaninogenica
E. Pseudomonasaeruginosa
Q1.13A42-year-oldpatientpresentswithsepticshockandisfoundtohaveasofttissue infection.WhichcomponentofthecellwallofGram-positivebacteriamay contributetothedevelopmentofsepticshockinGram-positiveinfections?
A.Capsularprotein
B.Endotoxin
C.Peptidoglycan
D.Phospholipid
E.Teichoicacid
Q1.14A23-year-oldfemalepresentswithaurinarytractinfection.Whichofthe followingistrueaboutureaseproducingbacteria?
A.Ureaseacidifiestheurinerenderingneutrophilsinactive
B. Escherichiacoli isureasepositive
C.Acidifyingtheurinecanleadtoprecipitationofstruvitecalculi
D. Morganellamorganii ispotentiallyaurea-splittingbacteria
E.Arecommensalorganismsthatpreventhepaticencephalopathy
Q1.15A63-year-oldfemaleisdiagnosedwithurosepsis.Sheisprofoundlyhypotensive. Whatisthemostimportantendotoxincomponentleadingtosepticshock fromGram-negativebacteria?
A.Lipopolysaccharidecoreoligosaccharides
B.Outermembranevesicles
C.LipidA
D.Oantigens
E.Capsule
Q1.16A21-year-oldfemalepresentswithnecrotisingfasciitis.Whichofthefollowingis notavirulencefactorof Staphylococcusaureus?
A.Lecthinase
B.Toxicshocksyndrometoxin-1
C.Panton-Valentineleukocidin
D.EnterotoxinA
E.DNase
Q1.17A31-year-oldmalereturnsfromEthiopiaandpresentswitharecurrentfebrileillness. Whatisthecauseoftherelapsingnatureoffeverin Borreliarecurrentis infection?
A.Antigenicdrift
B.Antigenicshift
C.Rapidlydevelopingantibodyresistance
D.Antigenicvariation
E.Encapsulation
Q1.18A16-year-oldmalepresentswithrespiratorydistress.Whichorganismproducesa toxinsimilarinactiontothatof Corynebacteriumdiphtheriae?
A. Bordetellapertussis
B. Pseudomonasaeruginosa
C. Serratiamarcescens
D. Haemophiliusinfluenzae
E. Clostridiumtetani
Q1.19An18-year-oldfemalepresentswithdifficultyswallowing.Athroatswabdemonstratesclub-shapedorganismswithdifferentialstaining. Corynebacteriumdiphtheriae issuspected.Whatare Corynebacteriumdiphtheriae volutingranulesmadeof?
A.Carbohydrate
B.Protein
C.Lipid
D.Phosphate
E.Collagen
Q1.20A45-year-oldfemalepresentswithaheartblockfollowingaminordogbitetothe palmofherhand(Figure1.3).
Figure1.3 Clinicalappearanceoftheright handfollowingaminordogbite.
Corynebacteriumulcerans isisolatedfromthewound,andanElektestispositive. Howdoesdiphtheriatoxinact?
A.ADPribosylationofEF2
B.Ergosterolsynthesisinhibition
C.Peptidoglycandisruption
D.Proteinsynthesisinhibitionattheribosome
E.Acetylcholineesteraseinhibition
Q1.21A50-year-oldmalewhounderwenttraumaticsplenectomytwoyearsago presentswithtachypnoea,tachycardiaandhypoxia.Amucoid Streptococcus pneumoniae issubsequentlygrown(Figure1.4).
Figure1.4 Growthonbloodagar incubatedinanaerobicenvironment at37°Cfor24hours.(Ablackand whiteversionofthisfigurewillappear insomeformats.Forthecolour version,pleaserefertotheplate section.)
Anavirulent,non-capsulatestrainofpneumococcuscanchangetovirulent capsulatestrainsthroughwhichmechanism?
A.Plasmidtransfer
B.Bacteriophage
C.NakedDNAtransformation
D.Homogenousrecombination
E.Slippedstrandmispairing
Q1.22A56-year-oldmaleisdiagnosedwithnativevalveendocarditis.Abloodculture growsaGram-positivecoccionbothbloodagarandMacConkeyagar,whichis ampicillinresistant.Whatisthelikelyidentificationofthisorganism?
A. Enterococcusfaecalis
B. Enterococcusfaecium
C. Streptococcuspneumoniae
D. Streptococcusbovis
E. Streptococcusanginosus
Q1.23A14-month-oldchildisadmittedwithatwo-weekhistoryofcoughingandis admittedwithsevereparoxysmsofcoughingleadingtohypoxia.Pertussisis suspected.Whichofthefollowingistrueabout Bordetellapertussis?
A.Polymorphonuclearleucocytosisseenduringinfection
B.Canbeclinicallydiagnosedinitiallywithindaysofonset
C.Organismisisolatedfromthethroatforseveraldaysfollowinginfection
D.Vaccinegiveslifelongimmunity
E.Tetracyclineiseffectiveintheparoxysmalstage
Q1.24A56-year-oldfemalewithurosepsisisnotimprovingdespitetreatmentwithan intravenousthird-generationcephalosporin.Whichbacteriaaremostlikelyto harbouranextended-spectrumbeta-lactamasegene?
A. Klebsiellapneumoniae
B. Enterobactercloacae
C. Citrobacterfreundii
D. Morganellamorganii
E. Proteusmirabilis
Q1.25A49-year-oldhomelesspatientattendstheemergencydepartmentcomplaining ofitchingandfever.Hedescribestheonsetoffeverapproximately7daysago.On examination,hehasawidespreadrashandexcoriationmarks.Whatisthe mostlikelyvectorforthisillness?
A. Aedesaegypti
B. Anophelesgambiae
C. Pediculushumanushumanus
D. Glossina spp.
E. Culex spp.
Q1.26A54-year-oldmalepresentswithaflittingrashandaneosinophiliaeightweeks afterreturnfromthetropics.Whichofthefollowinginfectionsrequirean intermediatesnailhost?
A.Diphylobothriasis
B.Schistosomiasis
C.Echinococcosis
D.Paragonamiasis
E.Strongyloidiasis
Q1.27A31-year-oldmalepresentswithdiarrhoeaseveraldaysafterreturnfrom Nigeria. Entamoeba isseenonstoolmicroscopy.Whichofthefollowingis anon-pathogenicvariantof Entamoebahistolytica?
A. Entamoebadispar
B. Escherichiacoli
C. Entamoebahartmanni
D. Endolimaxnana
E. Enterobactercloacae
Q1.28A21-year-oldfemalepresentswithafever,adenopathyandarash.Bloodtests demonstratealymphocytosis.Serologicaldiagnosisofaprimaryviralinfection maybemadebydetectionofwhichviral-specificimmunoglobulin?
A.IgA
B.IgD
C.IgE
D.IgM
E.IgG
Q1.29A23-year-oldmalestudenthasbeenrecentlyadmittedwithinvasivemeningococcal disease.Hehasmadeagoodrecoverybutgivesahistoryofapreviousepisode ofmeningococcalsepticaemiawhenhewas15yearsold.Thereisnohistoryof otherrecurrentinfections.Whichimmunodeficiencyismostlikelyinthispatient?
A.Adenosinedeaminasedeficiency
B.C7deficiency
C.Job’ssyndrome
D.Myeloperoxidasedeficiency
E.SelectiveIgMdeficiency
Q1.30An18-year-oldmalewithchronicgranulomatousdisease(CGD)hasrecurrent staphylococcalinfection.Whatisthemechanismbehindthis?
A.Chemotaxisinhibition
B.Defectinphagocyteoxidase
C.LackofC3dreceptor
D.Failureofphago-lysosomefusion
E.IgMdeficiency
Q1.31A63-year-oldfemaleisdiagnosedwithurosepsis.Sheisprofoundlyhypotensive. ThelipopolysaccharideofGram-negativebacteriaistheprincipleligandfor whichspecifictoll-likereceptor(TLR)?
A.TLR3
B.TLR4
C.TLR5
D.TLR7
E.TLR10
Q1.32A31-year-oldmalepresentswithacutehepatitis.HeisfoundtohavehepatitisC, butsubsequentlyclearsthisinfection.Whichpatternofcytokinesisproduced byTH1lymphocytes?
A.IL4andIL10
B.TNF-β andIL1
C.IL2andIFN-γ
D.IL1andIL12
E.IL4,IL5,IL6andIL13
Answers
A1.1 AnswerB:Anenvelope
Viruses(Latinfortoxin)containDNAorRNAbutnotboth.Thecentralribonucleiccore issurroundedbyaprotectiveshell(notacellwall)ofrepeatingproteinunitscalled capsomeres.Thishasasymmetrywhichiseitherhelicaloricosahedral.Viralparticles containpolymerasesandintegrasesbutnotruemetabolicpathways.Ascompletedvirions movefromthehostcellnucleustothecytoplasmorfromthecytoplasmtothe extracellularspace,anexternallipid-containingenvelopemaybeaddedtothe nucleocapsid.
FurtherReading
AbresciaNGA,BamfordDH,GrimesJM,StuartDI.Structureunifiestheviraluniverse. AnnRev Biochem. 2012;81:795–782.
A1.2 AnswerE:Parvoviridae
Thereareseveralmethodsofclassifyingviruses,butperhapsthemostwidelyusedis theBaltimoresystemdevelopedin1971,whichdesignatesvirusesintooneofseven groupsdependingonthenatureofthenucleicacidwithinthevirus.Fouraspectsare considered:(i)whetherthenucleicacidisDNAorRNA,(ii)whetheritissingle strandedordoublestranded,(iii)whetheritispositiveornegativesense,and(iv)the methodofreplication.
Table1 Classificationofviruses.
AdenoParvoReoPicornaOrthomyxoRetroHepadna
Herpes TogaParamyxo
Pox FlaviRhabdo
Papilloma
CoronaFilo
CaliciArena
HepeBunya
DatafromBaltimore(1971).
FurtherReading
BaltimoreD.Expressionofanimalvirusgenomes. BacteriolRev.1971;35(3):235–241.
A1.3 AnswerA:Single-stranded ( ) RNA
RSVisasingle-stranded( )RNAvirusofthefamilyParamyxoviridae.Infectionwiththis virususuallyproducesonlymildsymptoms,oftenindistinguishablefromcommoncold andminorillnesses.Itis,however,alsothemostcommoncauseofbronchiolitisand pneumoniainchildrenlessthan1yearofageandcanalsocausecroup.Thesesyndromes aremorelikelytooccurinpatientsthatareimmunocompromisedorinfantsborn prematurely.Noantiviralsareeffective – themainstayoftherapyisoxygen.Palivizumab(a monoclonalantibodyagainstRSVsurfacefusionprotein)canbegivenasmonthlyinjections begunjustpriortotheRSVseason(usuallyforfivemonths)asRSVprophylaxisforinfants thatareprematureorhaveeithercardiacorlungdisease.
FurtherReading
AndabakaT,NickersonJW,Rojas-ReyesMX,RuedaJD,BacicVrcaV,BarsicB.Monoclonalantibody forreducingtheriskofrespiratorysyncytialvirusinfectioninchildren. CochraneDatabaseSyst Rev. 2013;4:CD006602.
A1.4 AnswerD:Nipahvirus
Theparamyxoviridae(ss( )RNA)familyincludesvirusescausingmanycommon infections.However,ithasacomplextaxonomy:
SubfamilyParamyxovirinae
GenusHenipavirus(HendravirusandNipahvirus)
GenusMorbillivirus(Measlesvirus)
GenusRespirovirus(Humanparainfluenzaviruses1and3)
GenusRubulavirus(MumpsvirusandHumanparainfluenzaviruses2and4)
SubfamilyPneumovirinae
GenusPneumovirus(Humanrespiratorysyncytialvirus)
GenusMetapneumovirus(Humanmetapneumovirus)
RubellavirusisofthegenusRubivirusfromtheTogaviridaefamily(ss(+)RNA).Influenza BvirusisagenusoftheOrthomyxoviridaefamily(ss( )RNA).Poliovirusisofthegenus EnterovirusfromthePicornaviridaefamily(ss(+)RNA).ParvovirusB19isofthegenus ErythrovirusfromtheParvoviridaefamily.
FurtherReading
VirtueER,MarshGA,WangLF.Paramyxovirusesinfectinghumans:theold,thenewandthe unknown. FutureMicrobiol.2009;4(5):537–554.
A1.5 AnswerB:HPV-16andHPV-18areassociatedwithgenitalcancers HPVisaDNAvirusfromthepapillomavirusfamily,ofwhichtherearenumerousserotypes. Serotypes6and11mostfrequentlycauseano-genitalwarts,whileserotypes16and18are linkedwithano-genitalcancers.TheE6andE7earlyviralproteinsareconsidered oncogenic,inhibitingtumoursuppressiongenes:E6inhibitsp53,whileE7inhibitsp53,p21 andRB.DiagnosisisthroughPCRonsampleobtainedduringcolposcopy.
FurtherReading
CuttsFT,FranceschiS,GoldieS,CastellsagueX,deSanjoseS,GarnettG,EdmundsWJ,ClaeysP, GoldenthalKL,HarperDM,MarkowitzL.HumanpapillomavirusandHPVvaccines:areview. BullWorldHealthOrgan.2007;85(9):719–726.
A1.6 AnswerE:Erythrovirus
HumanscanbeinfectedbyvirusesfromthreegenerafromtheParvoviridaefamily,butno membersofthegenusParvovirusarecurrentlyknowntoinfecthumans.Thiscreatesa confusionoftermsbecausethehumanparvovirusesarenotingenusParvovirus.Theyare fromthegenera:Dependoviruses(e.g.Adeno-AssociatedVirus),Erythroviruses(e.g. ParvovirusB19)andBocaviruses.Inhealthyindividuals,themajorpresentationofB19 infectioniserythemainfectiosum,butinpatientswithunderlyinghaematologicaldisorders, infectioncanleadtoaplasticcrisis.Inimmunosuppressedpatients,persistentinfectionmay developthatpresentsaspureredcellaplasiaandsubsequentchronicanaemia.Inutero infectionmayresultinhydropsfetalis,miscarriageorcongenitalanaemia.
FurtherReading
RogoLD,Mokhtari-AzadT,KabirMH,RezaeiF.HumanparvovirusB19:areview. ActaVirol. 2014;58(3):199–213.
A1.7 AnswerD:HepatitisCvirus
Virusestypicallyhaveoneofthree naturalhistories;acuteinfection(e.g.influenza,hepatitisA, Hanta,Nipah,hepatitisE),latentinfection(e.g.herpessimplex,varicellazoster, cytomegalovirus)orchronicinfection(e.g.hepatitisB,hepatitisC,HIV).
TheglobalannualincidenceofhepatitisCisestimatedatfourmillion,ofwhom18–34% willspontaneouslyclearthevirus.AcuteinfectionwithhepatitisCisclinicallymildandmay evenbeunrecognisedorundiagnosed;acuteresolutionisnotassociatedwithanylong-term sequelae.TheremainderofthepatientsaredeemedtohavechronichepatitisC,whichis nowtheleadingcauseofend-stageliverdiseasesandliver-relateddeathsinmuchofthe world.ProgressionofliverfibrosisinchronichepatitisCisextremelyvariable,andis influencedbyviral,hostandenvironmentalfactors.
FurtherReading
WestbrookRH,DusheikoG.NaturalhistoryofhepatitisC. JHepatol.2014;61(S1):S58–S68.
A1.8 AnswerE:Iodide
ClinicalsamplesrequiringaGramstain,suchassterilefluidsandpositivebloodcultures,must beheatfixedtoaslide.AGramstaincanthenbeundertakentodeterminethepresenceof Gram-positiveorGram-negativebacteriaandtoenablemorphologicalcharacterisation.The slideshouldbefloodedwithcrystalvioletfor1minute,whichpenetratesthroughcellsandcell membrane.Thisisthenfollowedbyadditionofiodideforafurtherminute,whichalsoenters thecellwallandthenbindswiththecrystalviolet,forminglargermoleculeswhichare insolubleinwaterandarethereforefixedinplace.Adecolouriseristhenwashedovertheslide forafewseconds,intheformofeitheracetoneoralcohol,andtheslideisthenrinsedwith water.ThisdehydratesandthereforetightensthecellwallofGram-positiveorganisms, stoppingthelargecrystalviolate-iodinecomplexesfromexitingthecells.Contemporaneously thedecolouriserdegradestheoutermembraneofGram-negativeorganismsandthethincell wallcannotretainthecrystalviolet-iodinesolution.Acounterstainisthenappliedfor 1minute,usuallysafraninorcarbolfuchsin,whichcannotstainthedehydratedGram-positive organisms,butdoesadheretoGram-negativeorganisms.
Gram-positiveorganismshaveasinglecellmembrane,aroundwhichisathick peptidoglycancellwall.Gram-negativeorganismshaveathinpeptidoglycancellwall,but havetwocellmembranes,oneoneithersideofthecellwall.Cellwalldeficientbacteria cannotbereadilycharacterisedbytheGramstain.
FurtherReading
PublicHealthEngland.UKStandardsforMicrobiologyInvestigationsTP39:Stainingprocedures. 2015.Availableat: www.gov.uk/government/publications/smi-tp-39-staining-procedures
A1.9 AnswerC:Conjugation
Bacteriacandemonstrateresistancetoantimicrobialsthroughanumberofmechanisms, includingtargetalteration,enzymaticdestruction,porinlossandeffluxpumps.Thedifferent geneswhichdictatethesecellularmechanismscanbeconstitutivelypresentinsomegenera andspeciesofbacteria,or,morerarelymayarisethroughdenovomutationsinthose organismswhichdidnotpreviouslyharbourthem.Moreusuallyhowever,geneticmaterial encodingantimicrobialresistancemechanismsistransferredbetweenorganisms,eitherof thesamespecies,ofdifferentspeciesinthesamegenera,orlessfrequentlybetweengenera. Thistransferofgeneticmaterialcanoccurthroughthreemainmechanisms:transduction, transformationandconjugation(Figure1.5).
Figure1.5 Transmissionofgeneticmaterialbetweenmicroorganisms.
Inthiscase, Escherichiacoli doesnotconstitutivelyharbouranextended-spectrumbetalactamase(ESBL)geneintheirchromosomalgeneticmaterial,andthedevelopmentofade novoESBLgenewouldberare.Similarly,inthecontextofboththisorganism(E.coli)and thisfamilyofresistancegenes(ESBL),transductionandtransformationisunlikely.Instead, itisconjugation,andthetransmissionofplasmidswiththeiradditionalgeneticmaterial, whichwillbringtothehost E.coli lineagetheabilitytoproduceESBLproteinsandconfer resistancetomanypenicillinsandcephalosporins.
FurtherReading
HolmesAH,MooreLSP,SundsfjordA,SteinbakkM,RegmiS,KarkeyA,GuerinPJ,PiddockLJ. Understandingthemechanismsanddriversofantimicrobialresistance. Lancet.2016;387 (10014):176–187.
A1.10 AnswerA:Theisolateisnon-motile
Salmonella speciesarenon-lactosefermenting(withtheexceptionof Salmonella Arizonae and Salmonella Indiana)coliformswhichproducehydrogensulphide(withtheexceptionof someisolatesof Salmonella Paratyphi A and Salmonella Typhi)whensub-culturedinthe presenceofsulphur-containingaminoacids(onagarplatessuchasxylose-lysinedesoxycholateagar(XLD)ordesoxycholatecitrate(DCA)).
Twoantigensareexaminedwhenidentifyingserovarsofclinical Salmonella isolates; somatic(oligosaccharide) “O” antigensandflagella “H” antigens.Variationsintheseantigens
aididentificationforclinicalandepidemiologicalpurposes;however,laboratoryidentification canbecomplex. Salmonella isolatescanexistintwo “H” phases;phaseIbeingmotileand phaseIIbeingnon-motile(thelatterasinthiscase).Isolatesthatarenon-motileonprimary culturemaybeswitchedtoamotilephaseusingaCragietubeortheJamesonplate.
Somatic “O” antigensareheatstableandalcohol-resistant,butflagellar “H” antigensare heat-labile.Somesurfaceantigensin Salmonella maymasksomaticantigens,meaning bacteriawillnotagglutinatewithsomatic “O” antisera – onespecificsurfaceantigenisthe “Vi” antigen.The “Vi” antigenmayonlyoccurinthree Salmonella serovars(outofover 2000):Typhi,ParatyphiCandDublin,butisvariablydetected.Othernon-lactose fermentingcoliformscancausediarrhoea,including Shigella species,butasarulethesedo notproducehydrogensulphide.
FurtherReading
PublicHealthEngland.UKStandardsforMicrobiologyInvestigationsB30:Investigationoffaecal specimensforentericpathogens.2014.Availableat: https://assets.publishing.service.gov.uk/ government/uploads/system/uploads/attachment_data/file/343955/B_30i8.1.pdf
A1.11 AnswerE:Tumblingmotility
Neonatesareatagreaterriskofsepsisandmeningitisthanotheragegroupsdueto deficienciesinhumoralandcellularimmunityandinphagocyticfunction.Infantsyounger than32weeks’ gestationreceivelittlematernalimmunoglobulin.Inefficiencyinthe neonates’ alternativecomplementpathwaycompromisestheirdefenceagainstencapsulated bacteriaandpoormigrationandphagocyticfunctionofneutrophilsisapparent.Group B Streptococcus isthemostcommonlyidentifiedorganism,implicatedinroughly50%of cases,with Escherichiacoli accountingforafurther20%,meaningidentificationand treatmentofmaternalgenitourinaryinfectionsisanimportantpreventionstrategy. Listeria monocytogenes isthethirdmostcommonpathogen,causing5–10%ofcases.Patients exposedto L.monocytogenes inpregnancyoftendescribeamildflu-likeillnessbutthe organismexhibitstransplacentaltransmissionleadingtosepsisinbothmotherandneonate. Listeriaisacatalase-positive,haemolyticGram-positiverodthatexhibitstumblingmotility at25°Cbutnotat37°C.Tumblingmotilityisspecificto Listeria andidentifiedbythe hangingdroptest.Thecerebrospinalfluidresponseusuallyreflectstheintracellularnature of Listeria withapredominantmononuclearpleocytosis.
FurtherReading
NationalInstituteforHealthandCareExcellence.Neonatalinfection:antibioticsforpreventionand treatmentNICEguidance.2012.Availableat: www.nice.org.uk/guidance/cg149
A1.12 AnswerE: Pseudomonasaeruginosa
P.aeruginosa isanobligateaerobe.ItisaGram-negative,non-lactosefermentingorganism whichisoxidasepositive.Itisacommoncommensalinwounds,butcanbecomean opportunisticpathogen.
Bacteroides spp.(Gramnegative)and Clostridium spp.(Grampositive)areexamplesof non-spore-formingandspore-formingstrictanaerobes,respectively.Otherobligateanaerobes include Peptostreptococcus spp.and Veillonella spp. Bacteroidesmelaninogenicus hasrecently beenreclassifiedas Prevotellamelaninogenica while Porphyromonasgingivalis (commonly
foundintheoralcavity)wereoriginallyclassifiedinthe Bacteroides genus. Kluyvera spp.has beenputforwardasanewmemberoftheEnterobacterialesandassuchisonlyafacultative anaerobe. P.aeruginosa isanobligateaerobe.
FurtherReading
MooreLSP,CunninghamJ,DonaldsonH.Aclinicalapproachtomanaging Pseudomonasaeruginosa infections. BrJHospMed(Lond).2016;77(4):C50C54.
A1.13 AnswerE:Teichoicacid
TheoutsideofaGram-positivecellwalliscoveredwithathicklayerconsistingof peptidoglycan(PGN)andlipoteichoicacid(LTA),whichresemblesGram-negative lipopolysaccharide(LPS).LTAandPGNareabletoinducethereleaseofnitricoxide,IL-1, IL-6andTNF-α bymonocytesandmacrophagesandtoactivatetheoxidativeburstinvitro. Furthermore,theeffectsofLTAandPGNsmaybesynergistic.Lipoteichoicacidcanbindto CD14andtoTLR – bindingtoTLR-2hasshowntoinduceNF-kBexpression(acentral transcriptionfactor),elevatingexpressionofbothpro-andanti-apoptoticgenes.Its activationalsoinducesmitogen-activatedproteinkinases(MAPK)activation.LTAboundto targetscaninteractwithcirculatingantibodiesandactivatethecomplementcascadeto induceapassiveimmunekillphenomenon.Italsotriggersthereleasefromneutrophilsand macrophagesofreactiveoxygenandnitrogenspeciesandcytotoxiccytokines.Therefore, LTAsharesmanypathogenicsimilaritieswithendotoxins.
FurtherReading
GinsburgI.Roleoflipoteichoicacidininfectionandinflammation. LancetInfectDis. 2002;2(3):171–179.
A1.14 AnswerD: Morganellamorganii ispotentiallyaurea-splittingbacteria
Bacterialureasealkalinisesurine,andurease-producingbacteriaplayaprominentroleinthe formationofinfection-inducedurinarystones.Struvitestoneformationoccurswhen ammoniaproductionincreasesandurinepHelevatestodecreasethesolubilityofphosphate. Proteus spp., M.morganii and Klebsiellapneumoniae areallpotentiallyurea-splitting bacteria,whereaswhile E.coli isthemostcommoncauseoflowerurinarytractinfections,it isnotassociatedwithsignificantalkalinisation,norisinfectionwith Pseudomonas aeruginosa.Hyperammonaemiacanresultfromtheproductionofexcessiveamountsof ammoniaduetobacterialurease,anditssubsequentre-absorptionintothesystemic circulation,whichisimplicatedinhepaticencephalopathy.
FurtherReading
ClericettiCM,MilaniGP,LavaSAG,BianchettiMG,SimonettiGD,GianniniO.Hyper-ammonaemia associatedwithdistalrenaltubularacidosisorurinarytractinfection:asystematicreview. Pediatr Nephrol.2018;33(3):485–491.
A1.15 AnswerC:LipidA
EndotoxinsarepartoftheoutermembraneofthecellwallofGram-negativebacteria. Lipopolysaccharide(LPS)isamajorcomponentoftheoutermembrane,contributing greatlytothestructuralintegrityandprotectingthemembranefromchemicalattack.LPS
comprisesthreeparts:Oantigen,coreoligosaccharideandLipidA.LipidAisassociated withthetoxicityofGram-negativebacteria.Itistheinnermostofthethreeregionsofthe lipopolysaccharidemolecule,anditshydrophobicnatureallowsittoanchortheLPStothe outermembrane.LipidA(andLPS)isbelievedtoactivatecellsviatheToll-likereceptor system.Thepolysaccharidecomponentsproduceimmunogenicity.
FurtherReading
VanAmersfoortES,VanBerkelTJC,KuiperJ.Receptors,mediators,andmechanismsinvolvedin bacterialsepsisandsepticshock. ClinMicrobiolRev.2003;16(3):379–414.
A1.16 AnswerA:Lecthinase
S.aureus isacommonskincommensal,butcancauseskinandskinstructureinfections, includingcellulitisandnecrotisingfasciitis.Differentstrainsof S.aureus producevarious differentexotoxins,someofwhichareassociatedwithdifferingdiseasepresentationsand differingseverity.
Panton-Valentineleukocidin(PVL)isacytotoxinproducedby S.aureus which destroysneutrophilsandcausestissuenecrosis,recurrentskinandsofttissueinfectionsand necrotisingpneumonia.Toxicshocksyndrometoxin-1(TSST-1)isasuperantigenproduced by S.aureus whichstimulatesIL1,IL2andtumournecrosisfactorleadingtotoxicshock syndrome.EnterotoxinAcanresultintheemeticresponseseenin S.aureus foodpoisoning, butinadditionstaphylococcalenterotoxinsA,BandCarealsoassociatedwithtoxic-shock syndromepresentations.DNase(deoxyribonuclease)productionisoftenusedinmicrobiology laboratoriestodifferentiate S.aureus fromotherspeciesofstaphylococci(whichcanhydrolyse DNAforasourceofcarbon).
Severalbacteriaproducephospholipasesincluding Listeriamonocytogenes butnot S.aureus.Lecithinaseisatypeofphospholipaseproducedby Clostridiumperfringens causingmyonecrosisandhaemolysis.
FurtherReading
SpauldingAR,Salgado-PabónW,KohlerPL,HorswillAR,LeungDYM,SchlievertPM. StaphylococcalandStreptococcalsuperantigenexotoxins. ClinMicrobiolRev. 2013;26(3):422–447.
TongSY,DavisJS,EichenbergerEetal. Staphylococcusaureus infections:epidemiology, pathophysiology,clinicalmanifestations,andmanagement. ClinMicrobiolRev.2015;28 (3):603–661
A1.17 AnswerD:Antigenicvariation
Borreliarecurrentis (louse-bornerelapsingfever)arespirochaetes.Asinglespirochaetecan leadtoinfectionandmultiplyevery6–12hoursintheblood.Theorganismcaninvadethe brain,eye,liver,heartandotherorgans.Eachfebrileepisodeischaracterisedbymarked spirochaete-aemiafollowingwhichthereisclearanceofthecirculatingmicrobesanda developmentofantibodiesagainsttheantigensdisplayedduringtheepisode.Laterepisodes willinvolvespirochaetesdisplayingadifferentantigen,similartotrypanosomes,enabling reappearanceintheblood.Thisisaccomplishedthroughaprocessofantigenicvariation –specificallysite-specificrecombination.
Antigenicshiftandantigenicdriftarethemechanismsthroughwhichinfluenzachanges itsgeneticstructureandepitopesovertime.Slippedstrandmispairingcanfunctionas mechanismforphasevariationin Escherichiacoli.Transposonshavevariedrolesin infectiousdiseases,butperhapsofmostclinicalrelevanceareresponsiblefortransferofantimicrobialresistancegenes.
FurtherReading
ElbirH,RaoultD,DrancourtM.RelapsingfeverborreliaeinAfrica. AmJTropMedHyg. 2013;89(2):288–292.
BoutellisA,MediannikovO,BilchaKD,AliJ,CampeloD,BarkerSC,RaoultD. Borreliarecurrentis in headlice. Ethiopia.EmergInfectDis. 2013;19(5):796–798.
A1.18 AnswerB: Pseudomonasaeruginosa
Diphtheriatoxinisanexotoxinwhichisencodedbyabacteriophage.ItcatalysestheADPribosylationofeukaryoticelongationfactor-2(eEF2),inactivatingthisprotein.Inthisway,it actsasaRNAtranslationalinhibitor.TheexotoxinAof P.aeruginosa usesasimilar mechanismofaction.Itisanextremelypotentexotoxinwithonlyasingletoxinmolecule requiredtokillahumancell.
FurtherReading
van ‘tWoutEF,vanSchadewijkA,vanBoxtelR,DaltonLE,ClarkeHJ,TommassenJ,MarciniakSJ, HiemstraPS.Virulencefactorsof Pseudomonasaeruginosa induceboththeunfoldedproteinand integratedstressresponsesinairwayepithelialcells. PLoSPathog. 2015;11(6):e1004946.
A1.19 AnswerD:Phosphate
CorynebacteriumisnamedfromtheGreekword ‘Coryne’ whichreferstotheclubshapeof bacteria.Volutin,ormetachromaticgranules,arecytoplasmicgranuleslocatedinbacterial cytoplasm.Thesecontainpolymerisedmetaphosphateandrepresentsastorageformfor inorganicphosphateandenergy.Thesemetachromaticgranulesstainredwithmethyleneblue dyeandformsthebasisofAlbert’sstainforthemicrobiologicalidentificationof C.diphtheria.
FurtherReading
PallerlaSR,KnebelS,PolenT,KlauthP,HollenderJ,WendischVF,SchoberthSM. Formationofvolutingranulesin Corynebacteriumglutamicum. FEMSMicrobiolLett. 2005;243(1):133–140.
A1.20 AnswerA:ADPribosylationofEF2
Diphtheriatoxinisanexotoxinwhichisencodedbyabacteriophage.ItcatalysestheADPribosylationofeukaryoticelongationfactor-2(eEF2),inactivatingthisprotein. Toxin-mediatedsystemicsequelaeoccurinupto15%ofcases,predominantlyinrespiratory diphtheriabutalsointhosewithcutaneousdiphtheriawherediseaseisextensive.These manifestintwoways;myocarditisorperipheralneuropathy.Myocarditiscanleadto completeheartblockandcardiomyopathies.Toxin-mediatedneuropathiescanmanifestas bulbardysfunction,limbweaknessorrespiratoryfailure.Symptomscanbeprotracted – one seriesfoundsymptomspersistedforamedianof49days.
FurtherReading
MooreLSP,LeslieA,MeltzerM,SandisonA,EfstratiouA,SriskandanS. Corynebacteriumulcerans cutaneousdiphtheria. LancetInfectDis.2015;15(9):1100–1107.
A1.21 AnswerC:NakedDNAtransformation
S.pneumoniae isaGram-positivecocciwhichisacommonupperrespiratorytract commensal.Ithastheabilitytobecomepathogenichowever,andhasseveralvirulence factorstoaidthis.Onesuchvirulencefactoristheextracellularcapsule,whichresists phagocytosisbyhostimmunecells. S.pneumoniae canalteritsproductionofsuchcapsules throughphasevariation;aswitchbetweenallornoneproteinexpressionwhichisusually reversible.Thissystemcanbeusedtoadapttomorethanoneenvironmentandprovides mechanismstoevadethehostimmunesystem.Acrossdifferentgenera,phasevariation occursthroughseveralmechanisms:slipstrandmispairing(e.g.meningococcalcapsule formation),homologousrecombination,site-specificrecombination(e.g.DNAinversionin type1fimbrialvariationin Escherichiacoli ),epigenicregulation(e.g.alteredmethylationof regulatoryDNAregionsin E.coli outermembraneproteinformation)ortransformationof exogenousDNA(e.g.pneumococcalopacity,asinthiscase).
FurtherReading
EngholmDH,KilianM,GoodsellDS,AndersenES,KjærgaardRS.Avisualreviewofthehuman pathogen Streptococcuspneumoniae FEMSMicrobiolRev.2017;41(6):854–879.
A1.22 AnswerB: Enterococcusfaecium
EnterococcigrowwellonMacConkeyagarunlikestreptococci. E.faecalis aregenerally sensitivetoampicillinandresistanttoquinupristin/dalfopristin(synercid ®). E.faecium are resistanttoampicillinandsensitivetoquinupristin/dalfopristin.Thesecharacteristicsare usefulinlaboratoryidentificationofenterococci,howeverquinupristin/dalfopristinis difficulttoobtainforclinicaluseandisnotuniversallytestedinlaboratorypractice.
FurtherReading
PublicHealthEngland.StandardsforMicrobiologicalInvestigationID4:identificationof Streptococcusspecies,Enterococcusspeciesandmorphologicallysimilarorganisms.2014. Availableat: www.gov.uk/government/publications/smi-id-4-identification-of-streptococcusspecies-enterococcus-species-and-morphologically-similar-organisms
A1.23 AnswerC:Organismisisolatedfromthroatforseveraldaysfollowinginfection Bordetella spp.aresmallGram-negativecoccobacilliofthephylumproteobacteriaandare highlyfastidiousobligateaerobes. Bordetellapertussis isanexclusivehumanpathogen. Transmissionoccursbydirectcontactorrespiratoryaerosoldroplets.Itishighlycontagious withover90%ofhouseholdcontactsdevelopingdisease.Theincubationperiodaverages 7–10days(range5–21days).Activitytendstopeakattheagesof3–4years.Bacteria initiallyadheretociliatedepithelialcellsinthenasopharynxcausinganinitialcatarrhal phase,whichlastsfor1–2weeksduringwhichlargenumbersofbacteriacanberecovered fromthepharynx.Paroxysmsofcoughincreaseinfrequencyandseverityasillness progressesfor2–6weeks.Duringthisstagetoxinscauseciliostasisandfacilitatetheentry ofbacteriatotracheal/bronchialciliatedcells. B.pertussis alsoproducesalymphocytosis-
promotingfactor,whichcausesadecreaseintheentryoflymphocytesintolymphnodesand leadstoamarkedlymphocytosis.Complicationsincludepneumonia,seizuresand encephalitis.
Diagnosiscanbemadeviacultureoftheorganism,serologyormoleculardetection. AnasopharyngealswabcanbeculturedonBordet-Gengouagartoselectfortheorganism, whichshowsmercury-dropcolonies.Culturelackssensitivity,decreasingwithageand specimenquality.Itisunlikelytoculturepositiveafter2weeksofillness.Serologytesting detectsanti-pertussistoxinIgGantibodylevelsusingELISA.Thisisusedinolderchildren andadultsatleast14daysafteronsetofcough.Serologyisnotrecommendedwithinayear ofvaccination.GenomicdetectionbyPCRimprovessensitivity.Thiscanbeperformedon nasopharyngealswabsoraspiratesandisrecommendedonanyacutelyunwellchild <12 monthsofage.
Macrolideantibioticsarefirstlinetreatment.Antibiotictherapyhaslimitedeffecton improvingtheclinicalcoursebutpreventssecondarytransmission.In2007,aCochrane reviewshowedshortcourseareaseffective.Clarithromycinisrecommendedforneonates, erythromycininpregnancyandazithromycinforinfants,olderchildrenandadults.Neither vaccinationnornaturaldiseaseconferscompleteorlifelongprotectiveimmunityagainst pertussiswithimmunitywaningafter5–10years.In2012,anationalUKoutbreakwas declaredduetoincreasecasedetection.InresponsetheDepartmentofHealthintroducedan immunisationprogrammeforpregnantwomenbetween28and38weeksgestation. Boostingmaternalantibodieswouldthusleadtohigherneonatalantibodylevels.
FurtherReading
PublicHealthEngland.StandardsforMicrobiologicalInvestigationB6:Cultureofspecimensfor Bordetellapertussis and Bordetellaparapertussis.2014.Availableat: www.gov.uk/government/ publications/smi-b-6-investigation-of-specimens-for-bordetella-pertussis-and-bordetellaparapertussis
AltunaijiS,KukuruzovicR,CurtisN,MassieJ.Antibioticsforwhoopingcough(pertussis). Cochrane DatabaseSystRev. 2007;(3):CD004404.
A1.24 AnswerA: Klebsiellapneumoniae
K.pneumoniae isaGram-negativememberoftheEnterobacterialesfamily.Itisalactosefermentingcoliformandisacommoncommensalofthegastrointestinaltract.Ithasthe abilitytoacquireresistancemechanismsincludingplasmidmediatedESBLs.Thespreadof metallo-beta-lactamasessuchasKPC(Klebsiellaproducingcarbapenemases)andNDM (NewDelhiMetallo-beta-lactamase)within K.pneumoniae isofworldwideconcern. Enterobacter spp., Cfreundii and M.morganii canacquiresuchplasmid-mediated mechanisms,butmorecommonlyclinicallyrelevantantimicrobialresistanceisdueto AmblerclassCAmpCtypebeta-lactamases.
FurtherReading
JacobyGA,Munoz-PriceLS.Thenewbeta-lactamases. NEnglJMed. 2005;352(4):380–391. ThomsonKS.Extended-spectrum-beta-lactamase,AmpC,andCarbapenemaseissues. JClinMicrobiol.2010;48(4):1019–1025.
A1.25 AnswerC: Pediculushumanushumanus
Epidemictyphus(louse-bornetyphus)causesepidemicsfollowingwarsandnatural disasters.Thecausativeorganismis Rickettsiaprowazekii,transmittedbythehumanbody louse(PediculushumanushumanusalsoknownasPediculosishumanuscorporis)inits faeces.Thebodylouseis2–4mminlength,livesinclothesandlayseggsalongtheseams. Theincubationperiodofepidemictyphusis1–2weeks.Symptomsincludesevereheadache, asustainedhighfever,cough,rash,severemyalgia,hypotensionanddelirium.Therash beginsonthechestaboutfivedaysafterthefeverappears,andspreadstothetrunkand extremities.Louseinfestationisoftensufficientlytreatedbybathingthepatientandheat treatingtheclothesandbedlinen.Permethrintopicallyandoralivermectincanbeusedin persistentcases.Arandomisedtrialusingpermethrinimpregnatedunderwearinhomeless individualsfailedtoshowsustainedbenefit.
Glossina spp.areknownasTsetsefliesandtransmittrypanosomiasis. Aedesaegypti isthe vectorforvirusessuchasdengue,chikungunya,Zikaandyellowfever. A.gambiae isthe vectorformalaria. Culex spp.arethevectorsforWestNilevirus,Japaneseencephalitisand WesternandEasternEquineencephalitis.
FurtherReading
BenkouitenS,DraliR,BadiagaS,VeracxA,GiorgiR,RaoultD,BrouquiP.Effectofpermethrinimpregnatedunderwearonbodyliceinshelteredhomelesspersons:arandomizedcontrolledtrial. JAMADermatol. 2014;150(3):273–279.
A1.26 AnswerB:Schistosomiasis
The Diphyllobothriumlatum intermediatehostisacopepod(freshwatercrustacean)thena fish. Paragonamus spp.intermediatehostisacraborcrayfish. Echinococcus spp.(hydatid disease)hasanintermediatehostofsheep,goatsandswinewiththedefinitivehostof canines. Strongyloidesstercoralis afree-livingorganism.Eachhumaninfectingschistosome hasaspecificsnailspeciesforanintermediatehost: Schistosomamansoni with Biomphalaria spp.; Schistosomahaematobium and Schistosomaintercalatum with Bulinus spp.; Schistosomajaponicum with Oncomelania spp.; Schistosomamekongi with Tricula spp.
FurtherReading
GryseelsB,PolmanK,ClerinxJ,KestensL.Humanschistosomiasis. Lancet 2006;368:1106–1118. MooreLSP,ChiodiniPL.Tropicalhelminths. Medicine.2010;38(1):47–51.
A1.27 AnswerA: E.dispar
E.histolytica isthecausativeagentofintestinalamoebiasisleadingtoclinicalmanifestations ofamoebicdysenteryoramoebicliverabscesses. E.histolytica hasmicroscopicmorphological similaritywithtwootherspecies: E.dispar and Entamoebamoshkovskii.Entamoebadispar is non-pathogenicbut Entamoebamoshkovskii isreportedlyassociatedwithdiarrhoea,butits pathogenicpotentialremainsunclear.Thesecanbediagnosedbystoolsamplesbutitis impossibletodistinguishthethreespeciesbymicroscopyalone.Trophozoitesmaybeseenin afreshfaecalsmearandcystsinanordinarystoolsample.Antigentestscandistinguish betweenpathogenicandnon-pathogenicspecies.Moleculartechniques,suchasPCR,canbe usedbutarenotwidelyavailableinclinicalpractice.
FurtherReading
ParijaSC,MandalJ,PonnambathDK.Laboratorymethodsofidentificationof Entamoebahistolytica anditsdifferentiationfromlook-alike Entamoeba spp. TropParasitol.2014;4(2):90–95.
A1.28 AnswerD:IgM
Immunoglobulins,composedoftwoheavychainsandtwolightchainsinaYshape,bind antigensinavariabledomainandeffectfunctionsthroughaconstantdomain.Therearefive classesofconstantdomain,definingthefiveisotypesofimmunoglobulins:IgA,IgD,IgE, IgG,IgM.IgMimmunoglobulinsarethefirstisotypesexpressedduringB-celldevelopment; naïveB-cellsexpressIgMasamonomerontheircellsurface,thenoncestimulatedbyan antigenIgMisproducedasapentamerearlyinaprimaryviralinfection.However,the heavychainsinIgMhavenotundergonemuchsomaticmutationinresponsetoantigens, andtendtobemorepoly-reactivethanotherimmunoglobulinisotypes.IgGisthe predominantisotypeandareproducedbyactivatedB-cells(i.e.plasmacells)eitherpartway throughaprimaryviralinfection(replacingIgMproduction)oruponactivationofmemory B-cellsinresponsetolaterre-exposuresorreactivationofviralinfections.IgAoccursasa monomerinserumbutasadimerwhensecretedatmucosalsurfacesandinbreastmilk whereitactstoprotectthesemucosalsurfacesfromviruses,bacteriaandtoxins.IgEbinds withhighaffinitytomastcells,basophilsandeosinophilsonceactivatedbyanantigen –typicallyahelminth,althoughitisalsoassociatedwithhypersensitivityandallergic reactions.IgDfunctionsasanantigenreceptoronnaïveB-cellsandcanalsobindbasophils andmastcellsinrespiratoryimmunedefence.
FurtherReading
SchroederHW,CavaciniL.Structureandfunctionofimmunoglobulins. JAllergyClinImmunol. 2010;125(202):S41–S52.
A1.29 AnswerB:C7deficiency
Adenosinedeaminasedeficiencyisanautosomalrecessivemetabolicdisorder.Itleadsto severecombinedimmunodeficiency(SCID)in90%caseswithT,Bandnaturalkillercell dysfunction.Itcausesanaccumulationofdeoxyadenosine,whichcausesanincreasein S-adenosylhomocysteine;bothofwhicharetoxictoimmaturelymphocytesleadingtoa completelackofbothT-andB-cells.Prognosisispoorandacuterecurrentinfectionsoccur inparticular Pneumocystisjirovecii (PCP)pneumonia,candidiasis,herpeticinfections (CMV,EBV,VZV),parainfluenzaandenterovirus.Jobsyndrome(autosomaldominant hyperimmunoglobulinEsyndrome)ischaracterisedbyabnormallyhighlevelsof immunoglobulinE.Itclinicallyappearswithrecurrentskinabscesses,cysticlunginfections (primarily Staphylococcusaureus and Candida ),eczematousdermatitis,eosinophiliaand elevatedIgElevels.PatientswithC7deficiencyhavemarkedlydiminishedtotalhaemolytic complementactivityandlittleifanyC7isintheirserum.Serumbactericidalactivityis markedlyreducedandisresponsiblefortheincreasedriskof Neisseria spp.(especially Neisseriameningitidis)infections.ThecauseofIgMdeficiencyisunknownbutis characterisedbyanabsenceofIgMinthepresenceofnormallevelsofIgGandIgA.Serious recurrentbacterialinfectionscanoccurfrom Staphylococcusaureus,encapsulatedorganisms (Streptococcuspneumoniae, Haemophiliusinfluenzae )andviralinfections.
FurtherReading
CorviniM,RandolphC,AroninSI.ComplementC7deficiencypresentingasrecurrentaseptic meningitis. AnnAllergyAsthmaImmunol.2004;93(2):200–205.
A1.30 AnswerB:Defectinphagocyteoxidase
Phagocytesusenicotinamideadeninedinucleotidephosphate(NADPH)oxidasetogenerate reactivespeciesofoxygen.CGDiscausedbymutationsresultinginlossoffunctionin thisprocess.Neutrophils,monocytesandmacrophagesareunabletophagocytosebacteria suchas Staphylococcusaureus leadingtorecurrentbacterialinfections.
FurtherReading
ChiriacoM,SalfaI,MatteoGD,RossiP,FinocchiA.Chronicgranulomatousdisease:clinical, molecularandtherapeuticaspects. PediatrAllergyImmunol.2015;27(3):242–253.
A1.31 AnswerB:TLR4
TLRsaresurfacemoleculesoncellsthatdetectandreacttomicrobialantigens.Theligandsfor thesereceptorsarepartsofmicrobesandoftencalledpathogen-associatedmolecularpatterns (PAMPs).TLR4istheprinciplereceptorforLPSoftheGram-negativebacterium.TLR3binds double-strandedRNAproducedbymanyviruses.TLR5recognisesflagellaofbacteria.TLR7is similartoTLR8andbindsingle-strandedRNAfromvirusessuchasinfluenzaandHIV. TLR10functionisnotyetknown.
FurtherReading
TakeuchiO,HoshinoK,KawaiT,SanjoH,TakadaH,OgawaT,TakedaK,AkiraS.Differentialroles ofTLR2andTLR4inrecognitionofgram-negativeandgram-positivebacterialcellwall components. Immunity.1999;11(4):443–451.
A1.32 AnswerC:IL2andIFN-γ
ATH1-typeresponseisgenerallyassociatedwithkillingofintracellularorganisms,either virusesorbacteria.CytokinesassociatedwithaTH1responseare,therefore,typically pro-inflammatoryandactivatemacrophagesandinduceopsonising/complement-fixing immunoglobulinproductionbyB-lymphocytes.InterferongammaisoneofthemainTH1 cytokines.
ATH2-typeresponseoccurstypicallytocombatextracellularbacteriaandparasite.This leadstoactivationofeosinophils,basophilsanddendriticcellsthroughcytokinesincluding interleukins4,5and13,andadegreeofanti-inflammatoryresponsethroughinterleukin-10. InhepatitisC,bothIL-2andIFN-γ arekeycytokinesassociatedwithclearanceof acuteandchronicHCV.TheimpactofIL-2islikelyduetoitsroleindifferentiationof CD8+T-lymphocytesintoeffectorandlonglivedmemorycells.TheactivityofIFN-γ inhepatitisCislikelyattributabletoitsdirectroleininhibitingviralreplication. UntreatedpatientswithhepatitisCwhohaveprimaryclearanceofthevirusdisplayhigh magnitudeIL-2andIFN-γ responses.TreatedhepatitisCpatientswhodisplaysustained virologicalresponsehaveahighermagnitudeandmaintenancelevelsofIL-2andIFN-γ. Null-responderpatientsmayhavehighmagnitudeIFN-γ responsesearlyininfectionbut lackhighmaintenancelevels.
Table2 CytokineprofilesinTH1andTH2responses.
TH1TH2
MainpartnercellMacrophageBcell CytokinesIL-2,IFN-γ,TNF-β
Immunesystem stimulated
Maximisescellularimmunesystem (macrophagesandCD8+Tcells)
OtherfunctionsIFN-γ upregulatesIL-12(potentiating TH1further)anddownregulatesIL-4 (inhibitingTH2responses)
FurtherReading
IL-2,-4,-5,-6,-10,-13
Maximiseshumoralimmune system(Bcellantibody productionandclassswitching)
IL-10inhibitsIL-2,IL-12andIFN-γ production
FlynnJK,DoreGJ,HellardM,YeungB,RawlinsonWD,WhitePA,KaldorJM,LloydAR, FfrenchRA.MaintenanceofTH1HCV-specificresponsesinindividualswithacuteHCV whoachievesustainedvirologicalclearanceaftertreatment. JGastroenterolHepatol. 2013;28(11):1770–1781.